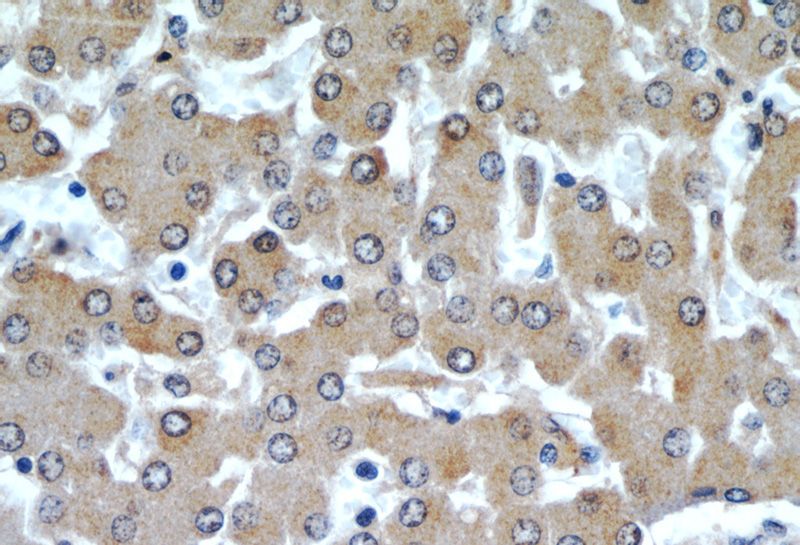
Immunohistochemical of paraffin-embedded human liver using Catalog No:108196(ARL13B antibody) at dilution of 1:50 (under 40x lens)

-
Product Name
ARL13B antibody
- Documents
-
Description
ARL13B Rabbit Polyclonal antibody. Positive IF detected in MDCK cells, hTERT-RPE1 , mouse embryonic fibroblasts, NIH/3T3 cells, NIH3T3 cells. Positive IHC detected in human liver tissue, human kidney tissue, human testis tissue. Positive IP detected in L02 cells. Positive WB detected in mouse liver tissue, L02 cells, mouse brain tissue, mouse kidney tissue, NIH/3T3 cells, Transfected HEK-293 cells. Observed molecular weight by Western-blot: 40-48 kDa, 66 kDa
-
Tested applications
ELISA, WB, IHC, IP, IF
-
Species reactivity
Human,Mouse,Rat, Dog; other species not tested.
-
Alternative names
ARL13B antibody; ARL2 like protein 1 antibody; ARL2L1 antibody; DKFZp686E2075 antibody; DKFZp686L2472 antibody; DKFZp686M2074 antibody; DKFZp761H079 antibody; JBTS8 antibody
- Immunogen
-
Isotype
Rabbit IgG
-
Preparation
This antibody was obtained by immunization of ARL13B recombinant protein (Accession Number: NM_144996). Purification method: Antigen affinity purified.
-
Clonality
Polyclonal
-
Formulation
PBS with 0.02% sodium azide and 50% glycerol pH 7.3.
-
Storage instructions
Store at -20℃. DO NOT ALIQUOT
-
Applications
Recommended Dilution:
WB: 1:500-1:5000
IP: 1:500-1:5000
IHC: 1:20-1:200
IF: 1:20-1:200
-
Validations

Immunofluorescent images of MDCK cells stained with ARL13B rabbit pAb (Catalog No:108196) and acetylated tubulin mouse mAb (Catalog No:107557) at dilution of 1:50, further stained with Alexa Fluor 488-congugated AffiniPure-Goat anti-Rabbit IgG(H+L) for Catalog No:108196, and Alexa Fluor 594-congugated AffiniPure Goat Anti-Rabbit IgG(H+L) for Catalog No:107557.

IF result of anti-ARL13B(Catalog No:108196) in NIH3T3 cell by Dr. Sudipto.

IF result of ARL13B antibody (Catalog No:108196) in hTERT-RPE cell fixed with 4% PFA or Methanol.

IF result from Dr. Corbit, Kevin. anti-ARL13B(Catalog No:108196) mark the cilium of Mouse embryonic fibroblasts.

mouse liver tissue were subjected to SDS PAGE followed by western blot with Catalog No:108196(ARL13B antibody) at dilution of 1:1000

Transfected HEK-293 cells were subjected to SDS PAGE followed by western blot with Catalog No:108196(ARL13B Antibody) at dilution of 1:1000

IP Result of anti-ARL13B (IP:Catalog No:108196, 3ug; Detection:Catalog No:108196 1:1000) with L02 cells lysate 2500ug.

Immunohistochemical of paraffin-embedded human liver using Catalog No:108196(ARL13B antibody) at dilution of 1:50 (under 10x lens)
Immunohistochemical of paraffin-embedded human liver using Catalog No:108196(ARL13B antibody) at dilution of 1:50 (under 40x lens)
-
Background
ARL13B, also named as ARL2L1, is a small ciliary G protein of the Ras superfamily. Localized in the cilia, it is required for cilium biogenesis and sonic hedgehog signaling. Defects in ARL13B are the cause of Joubert syndrome (JS) which is an autosomal recessive disorder characterized by a distinctive cerebellar malformation (PMID: 19906870).This antibody detects two specific bands at 60 kDa and 48 kDa. Arl13b is predicted to be a 48 kDa protein, and the 60 kDa band is likely to represent a modified form of Arl13b. ARL13B can be used to mark the cilia (PMID:22072986).
-
References
- Humbert MC, Weihbrecht K, Searby CC. ARL13B, PDE6D, and CEP164 form a functional network for INPP5E ciliary targeting. Proceedings of the National Academy of Sciences of the United States of America. 109(48):19691-6. 2012.
- Mukhopadhyay S, Wen X, Ratti N. The ciliary G-protein-coupled receptor Gpr161 negatively regulates the Sonic hedgehog pathway via cAMP signaling. Cell. 152(1-2):210-23. 2013.
- Liu C, Lin C, Whitaker DT. Prickle1 is expressed in distinct cell populations of the central nervous system and contributes to neuronal morphogenesis. Human molecular genetics. 22(11):2234-46. 2013.
- Gerhardt C, Lier JM, Kuschel S, Rüther U. The ciliary protein Ftm is required for ventricular wall and septal development. PloS one. 8(2):e57545. 2013.
- Kim JI, Kim J, Jang HS, Noh MR, Lipschutz JH, Park KM. Reduction of oxidative stress during recovery accelerates normalization of primary cilia length that is altered after ischemic injury in murine kidneys. American journal of physiology. Renal physiology. 304(10):F1283-94. 2013.
- Majumder S, Fisk HA. VDAC3 and Mps1 negatively regulate ciliogenesis. Cell cycle (Georgetown, Tex.). 12(5):849-58. 2013.
- Kuhns S, Schmidt KN, Reymann J. The microtubule affinity regulating kinase MARK4 promotes axoneme extension during early ciliogenesis. The Journal of cell biology. 200(4):505-22. 2013.
- Joo K, Kim CG, Lee MS. CCDC41 is required for ciliary vesicle docking to the mother centriole. Proceedings of the National Academy of Sciences of the United States of America. 110(15):5987-92. 2013.
Related Products / Services
Please note: All products are "FOR RESEARCH USE ONLY AND ARE NOT INTENDED FOR DIAGNOSTIC OR THERAPEUTIC USE"
